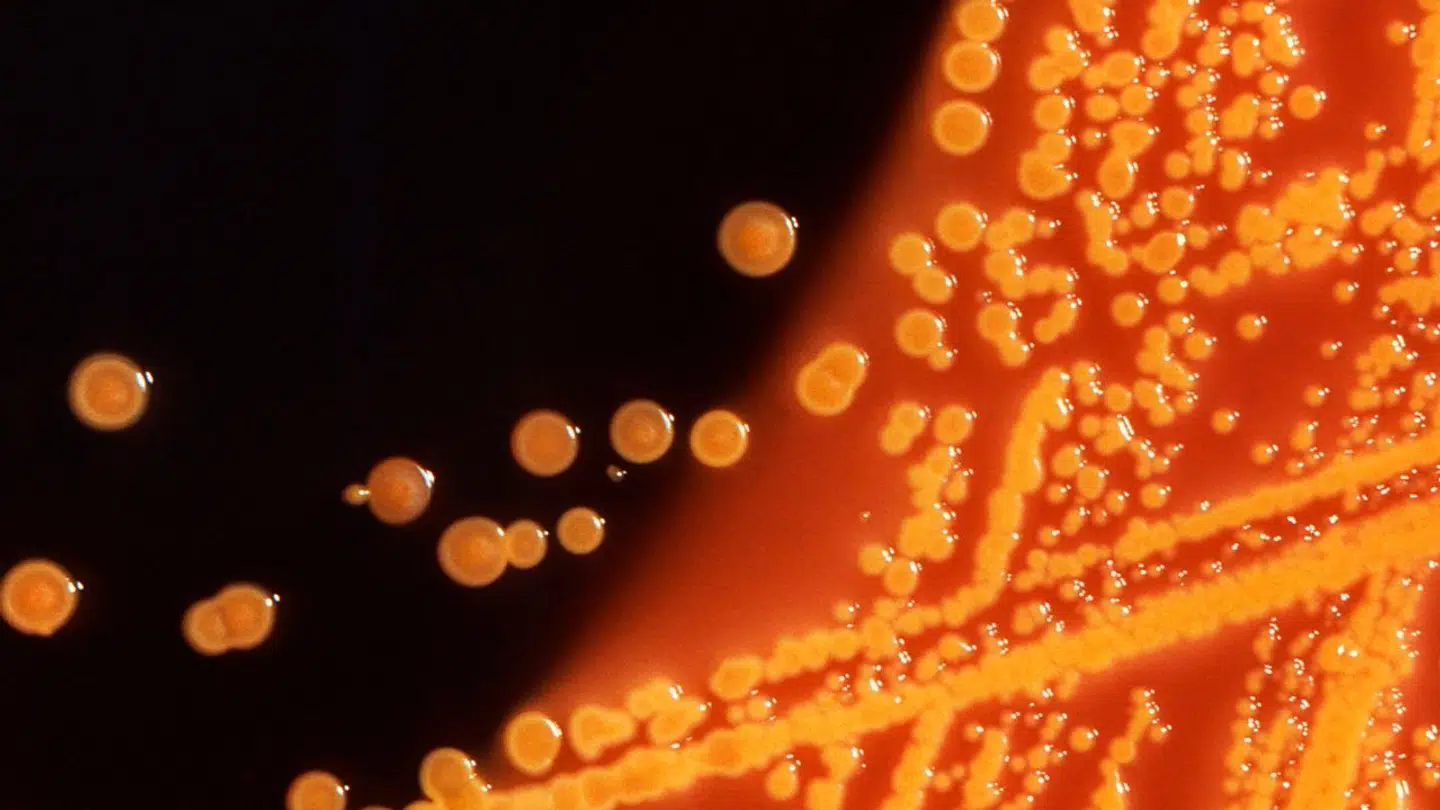
Amerikanske forskere har gjort sig en helt ny opdagelse, der kan forklare komplikationer vedrørende corona virus.

Nu kan nogle corona relaterede komplikationer måske blive forklaret.
Amerikanske forskere har nemlig gjort sig noget af et fund i deres forskning, der egentlig handlede om noget helt andet.
Det skriver Dagbladet.
»Det her er et særligt vigtigt studie. Studiet er især vigtigt, fordi det giver nogle overraskende resultater, der kan hjælpe med at forklare symptomer som 'hjernetåge' og andre neurologiske klager, der typisk rapporteres efter covid-19-infektion,« siger underdirektør i det norske Helsedirektorat, Espen Rostrup Nakstad.
Den nye forskning peger nemlig på, at nogle nerveceller, der udskiller dopamin, stopper med at fungere, når kroppen bliver smittet med corona.
Derfor begynder de i stedet at udskille stoffer, der forårsager betændelse.
Med denne nye viden kan flere coronakomplikationer endelig forklares.
Dopamin giver hjernen en følelse af belønning, og det har en central rolle for koncentrationen hos mennesker.
Skader på celler, der producerer dopamin, kan forklare flere kognitive problemer, som coronaviruspatienter har rapporteret, ifølge forskningen.
Ifølge mediet er det et helt særligt fund, som forskerne har gjort sig. De var i gang med at undersøge, hvordan forskellige celler som lungeceller, hjerteceller og leverceller reagerede på coronavirus.
Studiet er offentliggjort i det anerkendte tidsskrift Cell Stem Cell.